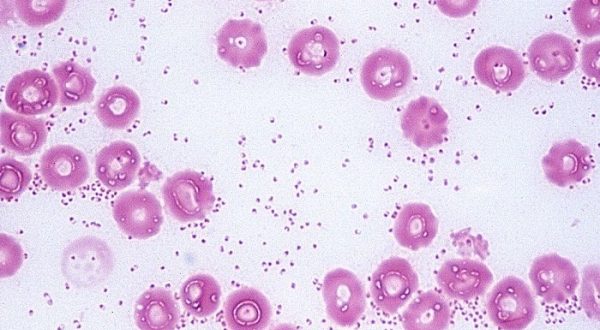

Разведение и выращивание кур
Как известно, птицеводы часто сталкиваются с проблемой резкой и внезапной заболеваемости кур. Кажется, вы строго придерживаетесь всех правил содержания и ухода, однако, проблема прогрессирует. Причиной всему могут стать болезнетворные
Каждый содержащий кур заводчик старается следить за здоровьем своих питомцев. Вопрос этот немаловажный, ведь куры, как правило, живут большим сплоченным коллективом и болезнь одной курицы может повлечь за
Иногда любители домашней птицы не заводят пернатых питомцев по той причине, что сильно опасаются за их здоровье и как лечить больную курицу не знают. Ведь в большинстве случаев
Почему у цыплят опускаются крылья? Этот вопрос тревожит многих заводчиков. Если у птиц на ферме наблюдается такой симптом, следует ли бить тревогу? Почему это происходит? При каких заболеваниях
Птицы очень часто подвержены различным заболеваниям, особенно когда речь идет о маленьких и беззащитных цыплятах, которые нуждаются в помощи заботливых хозяев. Узнайте, чем может помочь Эйметерм для цыплят,
Здоровье птиц для заводчика – вопрос первостепенной важности. Особенно уязвимыми считаются самые маленькие цыплята, но и взрослые особи могут подвергаться опасности со стороны болезнетворных вирусов и инфекций. Наиболее
Куриные яйца — продукт универсальный. Они являются основной составляющей многих блюд. Яйца домашних кур — вообще бесценный продукт. Из-за натуральных кормов они необычайно вкусны и полезны. Но что
Из-за массового применения химиопрепаратов, плохой экологии, а также вакцинации список инфекционных заболеваний резко переменился. Серьезную опасность в птицеводстве представляют заболевания, которые распространяются вследствие нарушений в содержании птиц. Одной
Глисты бывают не только у животных, но страдают от них и куры. При этом паразиты могут быть как внутри организма, так и в яйцах. Конечно, такие «незваные» гости не
Приобретя бройлеров, фермера ждут быстрого наращивания веса от птицы, при этом думают, что в этом процессе не будет никаких проблем. Но когда начинают замечать, что птенцы сидят на